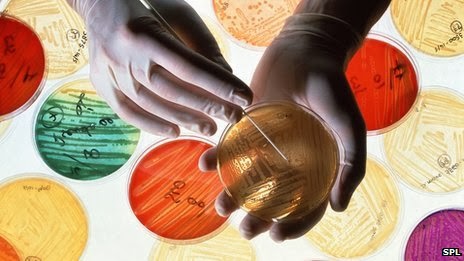

by Dr. Dana Sackett
Whether for an ear infection or something more serious, chances are we have all had to take antibiotics at one point in our lives. Despite this regular use of antibiotics, few people know where they come from or that our overuse of these drugs are causing some serious problems in our aquatic environment.
Antibiotics come from the chemical warfare that occurs between microscopic organisms that have developed natural defenses to protect themselves from other microscopic organisms. For example, penicillin, one of the earliest and most widely used antibiotics, was discovered when Sir Alexander Fleming observed that mold (Penicillium notatum) produced a natural substance that destroyed bacteria (Staphylococcus aureus) in 1928. Since this discovery, hundreds of these bacteria-killing substances have been discovered and many are synthesized and mass produced as our own personal weapon against disease causing bacteria.
![]() |
| (Source) |
The problem with this widespread use is that a large portion of the antibiotics consumed by people, or those used in fish farming and agriculture, make their way into our lakes, rivers, and oceans. At first glance, this may not seem like a big deal; the more antibiotics there are, the more the protection from those disease causing bacteria, right? Not exactly.
Not all bacteria are bad. Bacteria play a crucial role in the breakdown of waste when water is treated in our sewer system. Antibiotics can prevent useful bacteria from “cleaning” wastewater properly before it is released into the environment. For example, nitrification, a process which requires bacteria, is an important step in wastewater purification that eliminates toxic ammonia. The presence of antibiotics in wastewater can inhibit this process and may lead to the accumulation and release of a toxic form of nitrogen into the aquatic environment, potentially poisoning local aquatic species.
![]() |
| Wastewater treatment plants provide the perfect environment for antibiotic-resistant “superbugs” to be created and eventually released into streams and lakes. (Credit: Image courtesy of University of Michigan). |
Unpurified sewage water isn’t the only problem for aquatic species. Antibiotics can also cause collateral damage by killing microorganisms other than bacteria. Algae, particularly bluegreen algae, are frequently killed when antibiotics are released into the environment. Because algae often make-up the base of the food chain, even slight decreases in algae may affect aquatic ecosystems.
Another major concern with antibiotics in our water is resistance. Because many bacteria multiply rapidly (many can double their numbers every 20–30 minutes), continuous exposure to low levels of antibiotics can allow bacteria with a mutation to resist or survive the antibiotic to grow quickly and even share those resistant genes with other bacteria.
![]() |
| Commercial antibiotics are easily available for aquariums (Source) |
As a result, bacteria resistant to antibiotics have been seen in the environment with the potential to harm aquatic species and people. In particular, wastewater treatment plants and fish farming (aquaculture, mariculture) have been associated with the development of antibiotic resistance. Fish farming, where fish are frequently treated with antibiotics and kept enclosed with water that circulates to and from a local water source (e.g. river, ocean), is a specific concern because antibiotics can enter the environment directly without undergoing any kind of purification process.
![]() |
| A new system for aquaculture where water is not circulated to and from a local water source (traditional approach), but operates without any water exchange from the environment, preventing the release of antibiotics into local waterbodies. (Source) |
![]() |
| (Source) |
Fewer antibiotics in the natural environment ensures minimal collateral effects on other species and fewer opportunities for bacteria to develop resistance to the currently used antibiotics. With the prevalence of resistant bacteria spreading, scientists are searching for new antibiotics to combat the “superbugs”, but with very few new antibiotics being discovered and produced since the 1970’s, the race is on to find new drugs.
Be sure to Like The Fisheries Blog on Facebook and follow us on Twitter (@FisheriesBlog). Also, be sure to enter your email at the top right of this page to have us email you our weekly article.
References and more:
http://phys.org/news/2012-11-antimicrobial-resistance-fish-pathogenic-bacteria.html

This is very interesting and I learned a few things I wasn't aware of.